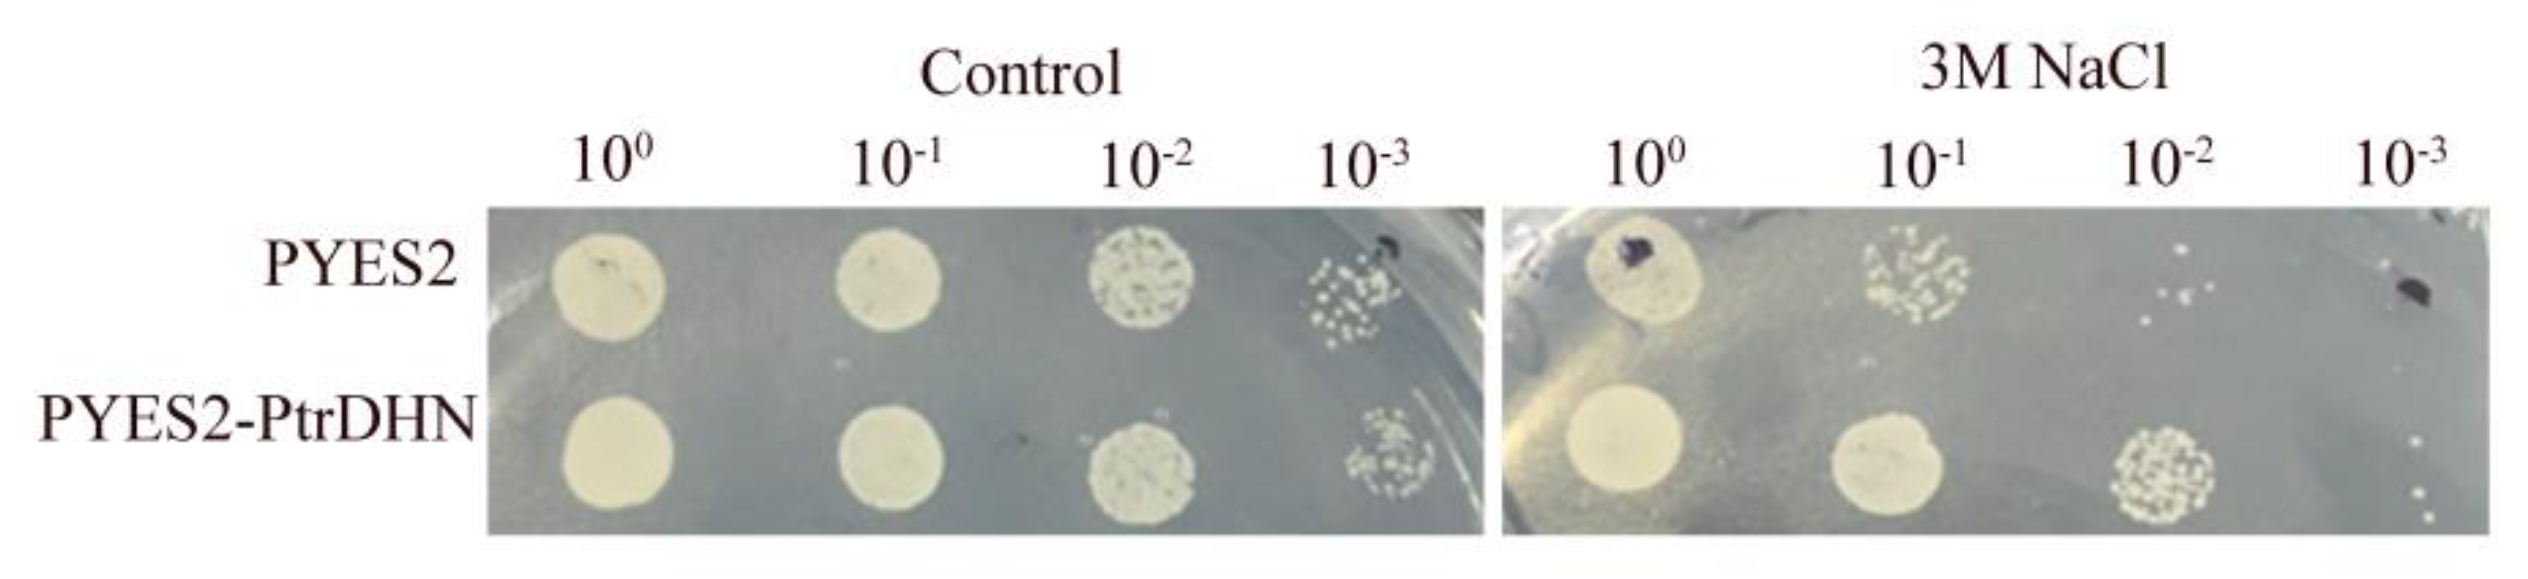

The Poplar (Populus trichocarpa) Dehydrin Gene PtrDHN-3 Enhances Tolerance to Salt Stress in Arabidopsis
Abstract
1. Introduction
2. Results
2.1. Phylogenetic Tree Analysis of PtrDHN-3
2.2. Characterization of Cis Elements in the PtrDHN-3 Gene Promoter
2.3. Analysis of PtrDHN-3 Expression under Abiotic Stress
2.4. PtrDHN-3 Improves Salt Tolerance in Yeast
2.5. Overexpression of PtrDHN-3 Increases Salt Tolerance in Arabidopsis
2.6. PtrDHN-3 Scavenges ROS
2.7. PtrDHN-3 Improves Biosynthesis of Proline under Salt Stress
3. Discussion
4. Materials and Methods
4.1. Populus Trichocarpa Cultivation and Stress Treatment
4.2. Cloning and Sequence Analysis of PtrDHN-3
4.3. RNA Isolation and qRT-PCR
4.4. Salt Stress Tolerance Assays in Yeast
4.5. Construction of Transgenic Arabidopsis
4.6. Salt Stress Tolerance Assays in Arabidopsis
4.7. Histochemical Detection of Reactive Oxygen Species (ROS)
4.8. Analysis of Antioxidant Enzyme Activity
4.9. Statistical Analyses
5. Conclusions
Supplementary Materials
Author Contributions
Funding
Institutional Review Board Statement
Informed Consent Statement
Data Availability Statement
Conflicts of Interest
References
- Boyer, J.S. Plant Productivity and Environment. Science 1982, 218, 443–448. [Google Scholar] [CrossRef] [PubMed]
- Blum, A. Drought resistance, water-use efficiency, and yield potential—Are they compatible, dissonant, or mutually exclusive? Crop Pasture Sci. 2005, 56, 1159–1168. [Google Scholar] [CrossRef]
- Landi, S.; De Lillo, A.; Nurcato, R.; Grillo, S.; Esposito, S. In field study on traditional Italian tomato landraces: The constitutive activation of the ROS scavenging machinery reduces effects of drought stress. Plant Physiol. Biochem. 2017, 118, 150–160. [Google Scholar] [CrossRef] [PubMed]
- Liu, N.Q.; Shen, Y.X.; Huang, B.R. Osmoregulants Involved in Osmotic Adjustment for Differential Drought Tolerance in Different Bentgrass Genotypes. J. Am. Soc. Hortic. Sci. 2015, 140, 605–613. [Google Scholar] [CrossRef]
- Dure, L., 3rd; Greenway, S.C.; Galau, G.A. Developmental biochemistry of cottonseed embryogenesis and germination: Changing messenger ribonucleic acid populations as shown by in vitro and in vivo protein synthesis. Biochemistry 1981, 20, 4162–4168. [Google Scholar] [CrossRef] [PubMed]
- Battaglia, M.; Olvera-Carrillo, Y.; Garciarrubio, A.; Campos, F.; Covarrubias, A.A. The enigmatic LEA proteins and other hydrophilins. Plant Physiol. 2008, 148, 6–24. [Google Scholar] [CrossRef] [PubMed]
- Hand, S.C.; Menze, M.A.; Toner, M.; Boswell, L.; Moore, D. LEA proteins during water stress: Not just for plants anymore. Annu. Rev. Physiol. 2011, 73, 115–134. [Google Scholar] [CrossRef] [PubMed]
- Allagulova, C.R.; Gimalov, F.R.; Shakirova, F.M.; Vakhitov, V.A. The plant dehydrins: Structure and putative functions. Biochemistry 2003, 68, 945–951. [Google Scholar] [CrossRef] [PubMed]
- Tunnacliffe, A.; Wise, M.J. The continuing conundrum of the LEA proteins. Naturwissenschaften 2007, 94, 791–812. [Google Scholar] [CrossRef]
- Drira, M.; Saibi, W.; Brini, F.; Gargouri, A.; Masmoudi, K.; Hanin, M. The K-segments of the wheat dehydrin DHN-5 are essential for the protection of lactate dehydrogenase and β-glucosidase activities in vitro. Mol. Biotechnol. 2013, 54, 643–650. [Google Scholar] [CrossRef]
- Malik, A.A.; Veltri, M.; Boddington, K.F.; Singh, K.K.; Graether, S.P. Genome analysis of conserved dehydrin motifs in vascular plants. Front. Plant Sci. 2017, 8, 709. [Google Scholar] [CrossRef] [PubMed]
- Riera, M.; Figueras, M.; Lopez, C.; Goday, A.; Pages, M. Protein kinase CK2 modulates developmental functions of the abscisic acid responsive protein Rab17 from maize. Proc. Natl. Acad. Sci. USA 2004, 101, 9879–9884. [Google Scholar] [CrossRef] [PubMed]
- Boddington, K.F.; Graether, S.P. Binding of a Vitis riparia dehydrin to DNA. Plant Sci. 2019, 287, 110172. [Google Scholar] [CrossRef]
- Close, T.J. Dehydrins: A commonality in the response of plants to dehydration and low temperature. Physiol. Plant 1997, 100, 291–296. [Google Scholar] [CrossRef]
- Hill, W.; Jin, X.L.; Zhang, X.H. Expression of an arctic chickweed dehydrin, CarDHN, enhances tolerance to abiotic stress in tobacco plants. Plant Growth Regul. 2016, 80, 323–334. [Google Scholar] [CrossRef]
- Bao, F.; Du, D.; An, Y.; Yang, W.; Wang, J.; Cheng, T. Overexpression of Prunus mume dehydrin genes in tobacco enhances tolerance to cold and drought. Plant Sci. 2017, 8, 151. [Google Scholar] [CrossRef]
- Liu, H.; Yu, C.; Li, H.; Ouyang, B.; Wang, T.; Zhang, J.; Wang, X.; Ye, Z. Overexpression of ShDHN, a dehydrin gene from Solanum habrochaites enhances tolerance to multiple abiotic stresses in tomato. Plant Sci. 2015, 231, 198–211. [Google Scholar] [CrossRef]
- Fernandez, M.; Valenzuela Águila, S.; Arora, R.; Chen, K. Isolation and characterization of three cold acclimation-responsive dehydrin genes from eucalyptus globulus. Tree Genet. Genomes 2012, 8, 149–162. [Google Scholar] [CrossRef]
- Celik Altunoglu, Y.; Baloglu, M.C.; Baloglu, P.; Yer, E.N.; Kara, S. Genome-wide identification and comparative expression analysis of LEA genes in watermelon and melon genomes. Physiol. Mol. Biol. Plants 2017, 23, 5–21. [Google Scholar] [CrossRef]
- Rorat, T.; Szabala, B.M.; Grygorowicz, W.J.; Wojtowicz, B.; Yin, Z.; Rey, P. Expression of SK3-type dehydrin in transporting organs is associated with cold acclimation in Solanum species. Planta 2006, 224, 205–221. [Google Scholar] [CrossRef]
- Ding, A.; Bao, F.; Zhang, T.; Yang, W.; Wang, J.; Cheng, T.; Zhang, Q. Screening of optimal reference genes for qRT-PCR and preliminary exploration of cold resistance mechanisms in Prunus mume and Prunus sibirica varieties. Mol. Biol. Rep. 2020, 47, 6635–6647. [Google Scholar] [CrossRef] [PubMed]
- Yu, Z.; Wang, X.; Mu, X.; Zhang, L. RNAi mediated silencing of dehydrin gene WZY2 confers osmotic stress intolerance in transgenic wheat. Funct. Plant Biol. 2019, 46, 877–884. [Google Scholar] [CrossRef] [PubMed]
- Guo, X.; Zhang, L.; Wang, X.; Zhang, M.; Xi, Y.; Wang, A.; Zhu, J. Overexpression of Saussurea involucrata dehydrin gene SiDHN promotes cold and drought tolerance in transgenic tomato plants. PLoS ONE 2019, 18, e0225090. [Google Scholar] [CrossRef] [PubMed]
- Nachbar, M.; Maul, J.; Stein, M.; Wätzig, H. Analysis of AtHIRD11 Intrinsic Disorder and Binding Towards Metal Ions by Capillary Gel Electrophoresis and Affinity Capillary Electrophoresis. J. Vis. Exp. 2018, 22, 57749. [Google Scholar] [CrossRef]
- Kirungu, J.N.; Magwanga, R.O.; Pu, L.; Cai, X.; Xu, Y.; Hou, Y.; Zhou, Y.; Cai, Y.; Hao, F.; Zhou, Z.; et al. Knockdown of Gh_A05G1554 (GhDHN_03) and Gh_D05G1729 (GhDHN_04) Dehydrin genes, Reveals their potential role in enhancing osmotic and salt tolerance in cotton. Genomics 2020, 112, 1902–1915. [Google Scholar] [CrossRef]
- Li, Q.; Zhang, X.; Lv, Q.; Zhu, D.; Qiu, T.; Xu, Y.; Bao, F.; He, Y.; Hu, Y. Corrigendum: Physcomitrella Patens Dehydrins (PpDHNA and PpDHNC) Confer Salinity and Drought Tolerance to Transgenic Arabidopsis Plants. Front. Plant Sci. 2018, 919. [Google Scholar] [CrossRef]
- Zhang, H.; Zheng, J.; Su, H.; Xia, K.; Jian, S.; Zhang, M. Molecular Cloning and Functional Characterization of the Dehydrin (IpDHN) Gene From Ipomoea pes-caprae. Front. Plant Sci. 2018, 11, 1454. [Google Scholar] [CrossRef]
- Szepesi, Á. Plant Metabolites and Regulation under Environmental Stress. Plants 2021, 25, 2013. [Google Scholar] [CrossRef]
- Székely, G.; Ábrahám, E.; Cséplő, Á.; Rigó, G.; Zsigmond, L.; Csiszár, J.; Ayaydin, F.; Strizhov, N.; Jásik, J.; Schmelzer, E.; et al. Duplicated P5CS genes of Arabidopsis play distinct roles in stress regulation and developmental control of proline biosynthesis. Plant J. 2008, 53, 11–28. [Google Scholar] [CrossRef]
- Liu, C.; Li, C.; Liu, B.; Ge, S.; Dong, X.; Li, W.; Zhu, H.; Wang, B.; Yang, C. Genome-wide Identification and Characterization of a Dehydrin Gene Family in Poplar (Populus trichocarpa). Plant Mol. Biol. Rep. 2012, 30, 848–859. [Google Scholar] [CrossRef]
- Chiappetta, A.; Muto, A.; Bruno, L.; Woloszynska, M.; Van Lijsebettens, M.; Bitonti, M.B. A dehydrin gene isolated from feral olive enhances drought tolerance in Arabidopsis transgenic plants. Front. Plant Sci. 2015, 30, 392. [Google Scholar] [CrossRef] [PubMed]
- Hinniger, C.; Caillet, V.; Michoux, F.; Ben Amor, M.; Tanksley, S.; Lin, C.; McCarthy, J. Isolation and characterization of cDNA encoding three dehydrins expressed during Coffea canephora (Robusta) grain development. Ann. Bot. 2006, 97, 755–765. [Google Scholar] [CrossRef] [PubMed][Green Version]
- Kirch, H.H.; van Berkel, J.; Glaczinski, H.; Salamini, F.; Gebhardt, C. Structural organization, expression and promoter activity of a cold-stress-inducible gene of potato (Solanum tuberosum L.). Plant Mol. Biol. 1997, 33, 897–909. [Google Scholar] [CrossRef]
- Wang, P.; Guo, Y.; Wang, Y.; Gao, C. Vacuolar membrane H+-ATPase c‘‘ subunit gene (ThVHAc‘‘1) from Tamarix hispida Willd improves salt stress tolerance. Plant Physiol. Biochem. 2020, 157, 370–378. [Google Scholar] [CrossRef]
- Djemal, R.; Khoudi, H. The ethylene-responsive transcription factor of durum wheat, TdSHN1, confers cadmium, copper, and zinc tolerance to yeast and transgenic tobacco plants. Protoplasma 2022, 259, 19–31. [Google Scholar] [CrossRef] [PubMed]
- Zang, D.; Wang, J.; Zhang, X.; Liu, Z.; Wang, Y. Arabidopsis heat shock transcription factor HSFA7b positively mediates salt stress tolerance by binding to an E-box-like motif to regulate gene expression. J. Exp. Bot. 2019, 15, 5355–5374. [Google Scholar] [CrossRef] [PubMed]
- Habib, I.; Shahzad, K.; Rauf, M.; Ahmad, M.; Alsamadany, H.; Fahad, S.; Saeed, N.A. Dehydrin responsive HVA1 driven inducible gene expression enhanced salt and drought tolerance in wheat. Plant Physiol. Biochem. 2022, 1, 124–133. [Google Scholar] [CrossRef] [PubMed]
- Gill, S.S.; Tuteja, N. Reactive oxygen species and antioxidant machinery in abiotic stress tolerance in crop plants. Plant Physiol. Biochem. 2010, 48, 909–930. [Google Scholar] [CrossRef]
- Zhang, H.F.; Liu, S.Y.; Ma, J.H.; Wang, X.K.; Haq, S.U.; Meng, Y.C.; Zhang, Y.M.; Chen, R.G. CaDHN4, a Salt and Cold Stress-Responsive Dehydrin Gene from Pepper Decreases Abscisic Acid Sensitivity in Arabidopsis. Int. J. Mol. Sci. 2019, 9, 26. [Google Scholar] [CrossRef]
- Luo, D.; Hou, X.; Zhang, Y.; Meng, Y.; Zhang, H.; Liu, S.; Wang, X.; Chen, R. CaDHN5, a Dehydrin Gene from Pepper, Plays an Important Role in Salt and Osmotic Stress Responses. Int. J. Mol. Sci. 2019, 23, 1989. [Google Scholar] [CrossRef]
- Kavi, K.P.B.; Sreenivasulu, N. Is proline accumulation per se correlated with stress tolerance or is proline homeostasis a more critical issue? Plant Cell Environ. 2013, 37, 300–311. [Google Scholar] [CrossRef] [PubMed]
- Nguyen, H.T.T.; Das Bhowmik, S.; Long, H.; Cheng, Y.; Mundree, S.; Hoang, L.T.M. Rapid Accumulation of Proline Enhances Salinity Tolerance in Australian Wild Rice Oryza australiensis Domin. Plants 2021, 28, 2044. [Google Scholar] [CrossRef] [PubMed]
- Tamura, K.; Peterson, D.; Peterson, N.; Stecher, G.; Nei, M.; Kumar, S. MEGA5: Molecular evolutionary genetics analysis using maximum likelihood, evolutionary distance, and maximum parsimony methods. Mol. Biol. Evol. 2011, 28, 2731–2739. [Google Scholar] [CrossRef] [PubMed]
- Lescot, M.; Déhais, P.; Thijs, G.; Marchal, K.; Moreau, Y.; Van de Peer, Y. PlantCARE, a database of plant cis-acting regulatory elements and a portal to tools for in silico analysis of promoter sequences. Nucleic Acids Res. 2002, 30, 325–327. [Google Scholar] [CrossRef]
- Livak, K.J.; Schmittgen, T.D. Analysis of relative gene expression data using real- time quantitative PCR and the 2-ΔΔCT method. Methods 2001, 25, 402–408. [Google Scholar] [CrossRef]
- Hilder, V.A.; Gatehouse, A.M.; Sheerman, S.E.; Barker, R.F.; Boulter, D. A novel mechanism of insect resistance engineered into tobacco. Nature 1987, 330, 160–163. [Google Scholar] [CrossRef]
- Lightenthaler, H. Chlorophylls and carotenoids: Pigments of photo synthetic biomembranes. Methods Enzymol. 1987, 148, 350–382. [Google Scholar]
- Fryer, M.J.; Oxborough, K.; Mullineaux, P.M.; Baker, N.R. Imaging of photo-oxidative stress responses in leaves. J. Exp. Bot. 2002, 53, 1249–1254. [Google Scholar]

Publisher’s Note: MDPI stays neutral with regard to jurisdictional claims in published maps and institutional affiliations. |
© 2022 by the authors. Licensee MDPI, Basel, Switzerland. This article is an open access article distributed under the terms and conditions of the Creative Commons Attribution (CC BY) license (https://creativecommons.org/licenses/by/4.0/).
Share and Cite
Zhou, M.; Peng, N.; Yang, C.; Wang, C. The Poplar (Populus trichocarpa) Dehydrin Gene PtrDHN-3 Enhances Tolerance to Salt Stress in Arabidopsis. Plants 2022, 11, 2700. https://doi.org/10.3390/plants11202700
Zhou M, Peng N, Yang C, Wang C. The Poplar (Populus trichocarpa) Dehydrin Gene PtrDHN-3 Enhances Tolerance to Salt Stress in Arabidopsis. Plants. 2022; 11(20):2700. https://doi.org/10.3390/plants11202700
Chicago/Turabian StyleZhou, Meiqi, Nafei Peng, Chuanping Yang, and Chao Wang. 2022. "The Poplar (Populus trichocarpa) Dehydrin Gene PtrDHN-3 Enhances Tolerance to Salt Stress in Arabidopsis" Plants 11, no. 20: 2700. https://doi.org/10.3390/plants11202700
APA StyleZhou, M., Peng, N., Yang, C., & Wang, C. (2022). The Poplar (Populus trichocarpa) Dehydrin Gene PtrDHN-3 Enhances Tolerance to Salt Stress in Arabidopsis. Plants, 11(20), 2700. https://doi.org/10.3390/plants11202700




